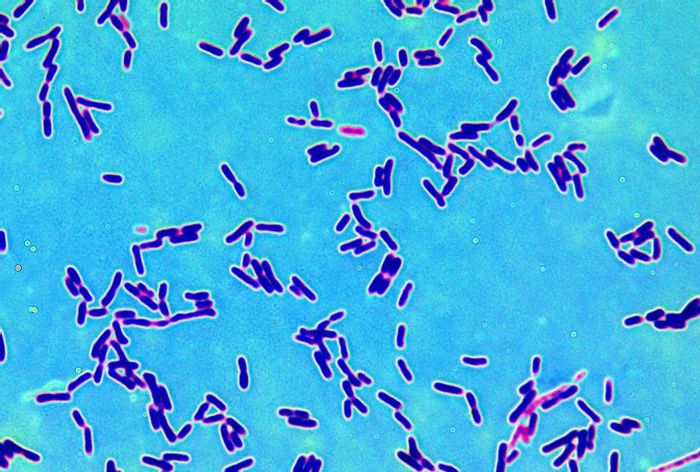

Imagenes De Las Bacterias Del Yogurt

Consumir yogures que contengan bacterias vivas que mejoran la digestión de la lactosa contenida en el yogur.
Imagenes de las bacterias del yogurt. La mezcla a menos de 50 ºc hará que las bacterias del yogurt se extiendan en nuestra leche y consigamos cuajarlo. Usi 4 8 es un alimento que generalmente está indicado para todas las personas. Después de hacer yogurt debes guardar uno porque los yogures caseros sirven para preparar más yogures hasta. Observación real de bacterias del yogurt normal y bífidus al microscopio.
Por la composición de yogurt el calcio es altamente biodisponible y el calcio es necesario para la formación y mant. Esta primera práctica titulada las bacterias del yogur tenía como principal objetivo apredenr a realizar un protocolo de tinción de bacterias para poder. Bulgaricus y streptococcus salivarius ssp. Busca millones de imágenes de bacterias de alta calidad a precios muy económicos en el banco de imágenes 123rf.
Ver las células de la mucosa bucal al microscopio duration. El yogur es un producto elaborado mediante fermentación de la leche utilizando un cultivo simbiótico de dos bacterias. Consumir alimentos que contengan lactosa en pequeñas cantidades a lo largo del día durante las comidas no más del equivalente a 2 cuencos de leche. Consumir quesos con bajo contenido de lactosa o sin lactosa.
Tinción para la observación de las bacterias del yogurt. Descarga fotos de bacterias. Podemos utilizar una yogurtera pero en caso de que no tengas hay otros métodos para mantener la temperatura correcta. Realizada por los alumnos de 1º de laboratorio de análisis clínico y biomédico y anatomía patológica de cesur sevilla.
Contiene más de cien millones de bacterias vivas que presentan una gran cantidad de vitaminas del grupo b. Su uso más corriente se ha aplicado en todo el mundo a los productos lácteos fermentados como el yogur el queso la mantequilla el kéfir y el koumiss constituyen un vasto conjunto de microorganismos benignos dotados de propiedades similares que fabrican.